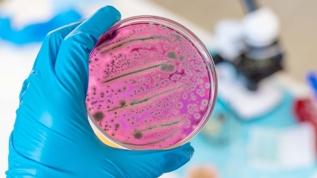
Görünmeyen tehlike! Bakteriler kimyasalları saklıyor

Pakistan'dan Türkiye açıklaması

Pakistan'ın eski Washington Büyükelçisi Mesud Han, askeri alanda Türkiye ile Pakistan arasında gemi, helikopter, SİHA ve diğer silah platformlarında yapılan anlaşmaların yanı sıra, Türk şirketlerinin ülkesinde saygın yatırımcılar olarak önemli bir yere sahip olduğunu söyledi.
Pakistan'ın eski Washington Büyükelçisi Mesud Han, ABD'nin Afganistan'dan çekilmesinin hemen ardından, kritik bir dönemde başlayan iki buçuk yıllık büyükelçilik görev sürecini AA muhabirine değerlendirdi.
Han, İkinci Dünya Savaşı'ndan sonra gerçekleşen "en iyi gelişme" olarak tanımladığı BM'nin, son yirmi yılda dünya barışı için oynadığı rolünün zayıfladığını ve Gazze gibi konularda uluslararası insancıl hukukun ve insan haklarının gözetilmesi hususunda etkisiz kaldığını belirtti.
BM'nin işleyişine ve önemli konularda oynadığı kritik rollere de yakinen tanıklık eden Han, kuruluşun yeniden güçlendirilmesinin dünyada istikrar için önemli olduğunu düşündüğünü kaydetti.

BM'nin iklim değişikliği veya sürdürülebilir kalkınma gibi konularda hala harika işler çıkardığını söyleyen Han, barışın ve güvenliğin sağlanması gibi konularda "zafiyet yaşadığını" ifade etti.
Ukrayna ve Gazze'de yaşanan çatışmalarda BM'nin rolünün zayıf kaldığını dile getiren Han, "Barış masasının merkezinde olması gerekiyordu. Bu iki bölgede barış ve güvenliğin temini için son kararı verebilecek güçte olmalıydı." dedi.
Han, İkinci Dünya Savaşı sonrası kurulan BM'nin yeni dünya düzenini temsil ettiğini kaydederek bunun, bazı prensipleri, insancıl hukuk ve insan hakları kurallarını ortaya çıkardığını ancak bunların, Gazze'de çiğnendiğini ifade etti.
"Hukukun uygulanması konusundaki bu çelişkiyi düzeltmemiz lazım." diyen Han, Gazze'de yaşananların kurulu dünya düzenine ve uluslararası kurallara bir meydan okuma olduğunu ve bunun dünyadaki dengeyi bozduğunu vurguladı.
- ABD VE PAKİSTAN İLİŞKİLERİ
Pakistan Dışişleri Bakanlığı Sözcülüğü, Pakistan'ın Pekin Büyükelçiliği, Pakistan'ın BM Daimi Temsilciliği ve Azad Cammu Keşmir Cumhurbaşkanlığı görevlerinde bulunmuş deneyimli bir diplomat olan Han, kariyerinin son durağı olan ABD'nin başkenti Washington'da, Amerikan askerlerinin Afganistan'dan çekildiği Ağustos 2021'in hemen ardından görevlendirildi.
ABD ordusunun bölgeden aniden çekilmesi sonrası oluşan boşluk ve bunun Washington ile ilişkilere yansımaları Han'ın, göreve gelir gelmez ilk gündem maddeleri oldu.
Başlarda sıkıntılı ve belirsizliğin gölgesinde bir süreç yaşadıklarını söyleyen Han, ABD ve Pakistan'ın 75 yılı aşkın müttefikliğini yeniden tanımlaması gerçeğinin ortaya çıktığını ve bu çerçevede iki ülke arasındaki stratejik işbirliğinin büyük ölçüde güncellendiğini belirtti.
Han, Ukrayna savaşının beklendiği gibi kısa sürede sonuçlanmayacağının ortaya çıktığını ve dünyayı Pakistan'ı da içeren geniş bir şekilde etkilediğini kaydetti.
ABD'nin, Çin'e karşı Hindistan ile giriştiği Hint-Pasifik Stratejisi'nin, Pakistan'ı dışlayarak bölgede sağlıklı ve sürdürülebilir bir çözüm üretemeyeceğinin altını çizen Büyükelçi Han, bölgesel istikrar, barış ve refahın artmasının ancak Washington'un bölgede adil bir düzenin kurulmasına katkı sunmasıyla mümkün olacağını aksi takdirde "bölge istikrarını sabote etmeyi hedefleyen güçlerin" faaliyet göstermesine olanak sağlayacağı değerlendirmesinde bulundu.
Han, ABD'nin 2021'de Afganistan'dan çekilmesinin Pakistan-ABD ilişkilerini "belirsiz bir atmosferin gölgesinde" bıraktığını ve son dönemde bu ilişkilerin gözden geçirilerek yeni esaslar üzerine yapılandırıldığını aktardı.
Rusya'nın 1980'li yıllarda Afganistan'daki varlığı nedeniyle Pakistan-ABD arasında gelişen işbirliğinin, Rusya'nın Afganistan'dan çekilmesiyle benzer bir dönem yaşadığını dile getiren Han, ABD'nin Afganistan'dan çekilmesi sonrasında değişen dinamiklere göre, Washington ile işbirliklerinin yeniden şekillendiği kaydetti.
- "YENİ DÖNEMDE GÜVENLİKÇİ POLİTİKALAR KADAR EKONOMİK İLİŞKİLER DE ÖNE ÇIKACAK"
ABD'nin, 2021'de Afganistan'dan çekilmesinin ardından ülkede büyük ölçüde istikrarın sağlandığını savunan Han, geçici Afgan yönetiminin bu konuda attığı bazı adımların etkili olduğunu belirtti.
Han, "Pakistan Talibanı (TTP) ve DEAŞ-K gibi terör örgütlerinin Afganistan topraklarını kullanarak Pakistan'ı hedef alan saldırılar düzenlemeye devam ettiğini" ve bunun engellenmesi konusunda Kabil yönetimi ile görüşmelerin sürdüğünü söyledi.
ABD'nin bölgeyi terk ettiğini ancak terör tehlikesinin devam ettiğini dile getiren Han, bununla mücadele etmenin iki ülkenin ortak sorumluluğu olduğunu vurguladı.
Han, Pakistan-ABD ilişkilerinde yeni dönemde yatırımlar alanında işbirliğinin güvenlikçi politikalardan daha büyük öneme sahip olacağını belirterek, iki ülke ilişkisinin teknoloji, ticaret, tarım, enerji ve iklim değişikliği gibi konulara odaklanılacağını aktardı.
İki ülke arasındaki ilişkilerin güçlü bağlara dayandığını söyleyen Han, bölgesel güvenlik ve stratejik işbirlikleri olmasa da iki ülke arasındaki ilişkilerin başka alanlarda geliştiğini ve ani değişimlere dayanıklı olduğunu savundu.
- ASKERİ VE TİCARİ ALANDA GELİŞEN TÜRKİYE-PAKİSTAN İLİŞKİLERİ
Washington görevi sırasında Türkiye'nin eski Washington Büyükelçi Murat Mercan ve Büyükelçi Sedat Önal ile aynı dönemlerde çalışan Büyükelçi Han, Türk mevkidaşları ile büyük bir uyum içinde çalıştıklarını ve Türkiye'nin Pakistan ile ilişkilerini çok yönlü şekilde geliştirdiğini belirtti.
Keşmir asıllı Han, askeri alanda iki ülke arasında gemi, helikopter, SİHA ve diğer silah platformlarında yapılan anlaşmaların yanı sıra, Türk şirketlerinin Pakistan'da saygın yatırımcılar olarak önemli bir yere sahip olduğunu söyledi.
Türkiye'nin Pakistanlı yatırımcılar için çok önemli kolaylıklar ve fırsatlar sunduğunu dile getiren Han, Pakistan kökenli ABD firmalarının da Türkiye'de önemli yatırımları olduğunu dile getirdi.
- Popüler Haberler -

Type 10 tankında tatbikat faciası: Japon askerler hayatını kaybetti

"ABD, İran'ın nükleer programına 10 yıllık moratoryuma 'şartlı olarak istekli'"

Neden beygir gücü ile hesaplıyoruz? Otomotiv dünyasını nasıl değiştirdi?

Arjantin kongresinden Milei'nin buzul yasasına onay çıktı! Çevreciler ayakta

Bilim dünyası şaşkın! Felaket sandığımız şey çözüm mü?

Katar: Hürmüz krizi devam ederse bu bölgesel boyuttan çıkarak küresel bir hal alır